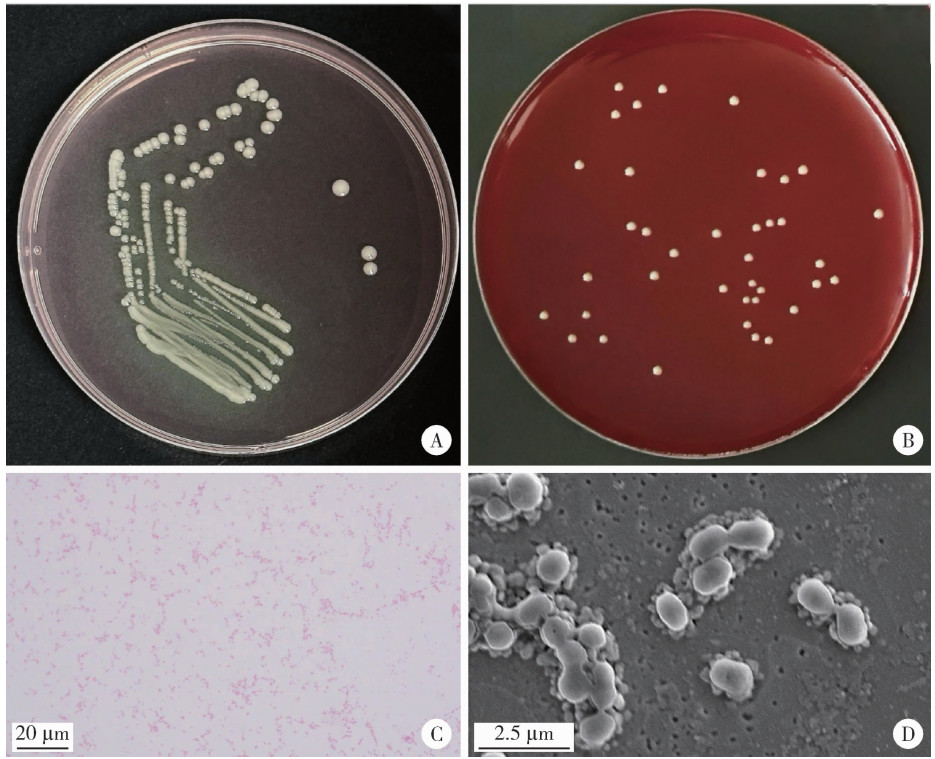

Journal of Peking University (Health Sciences) ›› 2026, Vol. 58 ›› Issue (1): 50-59. doi: 10.19723/j.issn.1671-167X.2026.01.007
Previous Articles Next Articles
Isolation, identification, and metabolic characterization of a Veillonella parvula isolated from supragingival plaque in a patient with rampant caries
Ziyu HE1, Hui ZHANG1, Zhibin CHEN2, Haixia XING1,*( ), Jie PAN1,*(
), Jie PAN1,*( )
)
- 1. Department of General Dentistry, Peking University School and Hospital of Stomatology & National Center for Stomatology & National Clinical Research Center for Oral Diseases & National Engineering Research Center of Oral Biomaterials and Digital Medical Devices, Beijing 100081, China
2. Department of Periodontology, Peking University School and Hospital of Stomatology & National Center for Stomatology & National Clinical Research Center for Oral Diseases & National Engineering Research Center of Oral Biomaterials and Digital Medical Devices, Beijing 100081, China
CLC Number:
- R781.4
| 1 |
doi: 10.1016/j.jdent.2023.104557 |
| 2 |
doi: 10.1111/scd.12986 |
| 3 |
doi: 10.1186/s12903-024-04150-8 |
| 4 |
doi: 10.1007/s10067-024-06958-9 |
| 5 |
doi: 10.1177/08959374940080022001 |
| 6 |
|
| 7 |
doi: 10.1186/s12903-023-02722-8 |
| 8 |
doi: 10.7717/peerj.5649 |
| 9 |
doi: 10.3390/jcm12041559 |
| 10 |
|
| 11 |
doi: 10.1128/spectrum.04318-23 |
| 12 |
doi: 10.1128/jb.105.3.999-1005.1971 |
| 13 |
doi: 10.1016/0003-9969(75)90224-1 |
| 14 |
doi: 10.3389/froh.2021.774115 |
| 15 |
doi: 10.3389/fmicb.2021.661509 |
| 16 |
doi: 10.1016/j.anaerobe.2014.05.003 |
| 17 |
doi: 10.1016/j.archoralbio.2019.104578 |
| 18 |
doi: 10.1111/1751-7915.14547 |
| 19 |
doi: 10.1128/JB.00983-08 |
| 20 |
doi: 10.1016/j.chom.2025.07.019 |
| 21 |
doi: 10.1002/imt2.23 |
| 22 |
doi: 10.1177/0022034520914519 |
| 23 |
doi: 10.1128/AEM.01262-20 |
| 24 |
doi: 10.1159/000260324 |
| 25 |
doi: 10.1128/iai.00355-22 |
| 26 |
doi: 10.1016/j.cub.2025.02.044 |
| 27 |
doi: 10.1111/j.1574-6968.2007.00701.x |
| 28 |
doi: 10.1186/s12903-023-02738-0 |
| 29 |
doi: 10.1177/0022034513504218 |
| [1] | Xinxin CHEN, Zhe TANG, Yanchun QIAO, Wensheng RONG. Caries experience and its correlation with caries activity of 4-year-old children in Miyun District of Beijing [J]. Journal of Peking University (Health Sciences), 2024, 56(5): 833-838. |
| [2] | ZHAO Si-ming,ZHAO Xiao-han,ZHANG Jie,WANG Dang-xiao,WANG Xiao-yan. Preliminary evaluation of a virtual reality dental simulation system on training of caries identification ability [J]. Journal of Peking University (Health Sciences), 2021, 53(1): 139-142. |
| [3] | Xiao-xian CHEN,Jie ZHONG,Wen-juan YAN,Hong-mei ZHANG,Xia JIANG,Qian HUANG,Shi-hua XUE,Xing-gang LIU. Clinical performance of rensin-bonded composite strip crowns in primary incisors [J]. Journal of Peking University (Health Sciences), 2020, 52(5): 907-912. |
| [4] | Qiong ZHOU,Chu-fang PENG,Man QIN. Near-infrared light transillumination for detection of incipient proximal caries in primary molars [J]. Journal of Peking University(Health Sciences), 2019, 51(1): 59-64. |
| [5] | YAN Wen-juan, ZHENG Jia-jia, CHEN Xiao-Xian. Application of fluoride releasing flowable resin in pit and fissure sealant of children with early enamel caries [J]. Journal of Peking University(Health Sciences), 2018, 50(5): 911-914. |
| [6] | WANG Xiao, WANG Xin, QIN Man. A preliminary study of saliva matrix metalloproteinases (MMP-2 and MMP-9) in children with caries [J]. Journal of Peking University(Health Sciences), 2018, 50(3): 527-531. |
| [7] | YU Jiang-li,TANG Ren-tao,FENG Lin,DONG Yan-mei. Digital imaging fiber optic transillumination (DIFOTI) method for determining the depth of cavity [J]. Journal of Peking University(Health Sciences), 2017, 49(1): 81-085. |
| [8] | PAN Hui,CHENG Can,HU Jia,LIU He,SUN Zhi-hui. Bond strengths of absorbable polylactic acid root canal post with three different adhesives [J]. Journal of Peking University(Health Sciences), 2015, 47(6): 990-993. |
| [9] | ZHAO Xiao-yi, GAO Xue-jun. Surface roughness and staining stability of infiltrant resin for enamel white spot lesion [J]. Journal of Peking University(Health Sciences), 2014, 46(1): 53-57. |
| [10] | REN Wen, CHEN Feng, ZHANG Yi-fei, ZHANG Qian, WANG Xiao-yan, LIU Ying-yi, YUAN Chong-yang, MA Qing-wei, XU Tao, ZHENG Shu-guo. Identification of Streptococcus mutans in carious patients’ saliva samples by MALDI-TOF mass spectrometry [J]. Journal of Peking University(Health Sciences), 2014, 46(1): 25-29. |
|
||